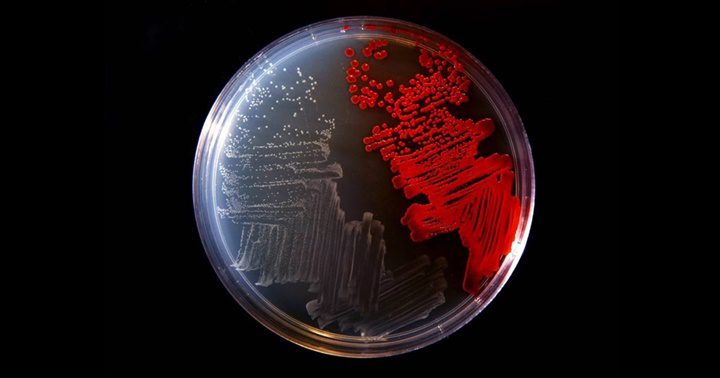
Bacterias 1

Hasta un tercio de las bacterias de la boca. Bacterias ‘Helicobacter pylori’ al microscopio.
Los resultados sugieren que algunas enfermedades consideradas no transmisibles, como el cáncer, podrían tener un componente contagioso por los microorganismos del aparato digestivo
Hay un hecho desasosegante: en el cuerpo de una persona hay más células bacterianas (38 billones) que humanas (30 billones). Uno de los popes de la microbiología, el estadounidense Frederic Bushman, invita incluso a dejar de ver al ser humano como un organismo individual y a considerarlo más bien como un arrecife de coral habitado por otros billones de seres. Un macroestudio revela ahora que esos diminutos inquilinos saltan de una persona a otra en enormes proporciones: dos convivientes comparten el 12% de las cepas de sus intestinos y hasta el 32% de su boca, incluidas bacterias asociadas a problemas como el cáncer, la obesidad, la diabetes y las enfermedades cardiovasculares, según explica la primera firmante de la investigación, la microbióloga española Mireia Vallès. Algunas enfermedades consideradas históricamente no transmisibles tienen un componente contagioso. Es un cambio de paradigma, proclama Vallès.
El nuevo estudio ha analizado muestras de heces y saliva de unas 5.000 personas de 20 países en cinco continentes. Los resultados constatan que las interacciones sociales determinan la composición del denominado microbioma, incluso en las tripas. Una madre comparte con sus hijos pequeños un 34% de las cepas bacterianas de su intestino. Dos personas convivientes, un 12%. Dos hermanos gemelos que residen en casas diferentes, un 8%. Y dos adultos independientes de una misma ciudad, también un 8%. Los microorganismos heredados se van perdiendo tras el parto: es la convivencia la que marca el microbioma. El porcentaje que un adulto comparte con su madre es igual al que comparte con personas con las que vive o con compañeros de trabajo, señala Vallès, de la Universidad de Trento, en Italia.


Imagen del microbioma intestinal
Tres de cada cuatro muertes en el mundo se producen por las llamadas enfermedades no transmisibles, como el cáncer, los infartos de miocardio, el ictus, la diabetes y el asma. Más de 40 millones de personas fallecen cada año en el mundo por estas causas, según la Organización Mundial de la Salud. El microbiólogo canadiense Brett Finlay lanzó hace tres años una hipótesis provocadora. ¿Son transmisibles las enfermedades no transmisibles?, se preguntó en la revista Science. Finlay argumentó que factores como la comida basura, el tabaquismo y el consumo de alcohol provocan un desequilibrio en el microbioma, que puede influir en las enfermedades no transmisibles o en sus factores de riesgo, como la obesidad. Ese microbioma alterado se podría transmitir entre personas, contribuyendo potencialmente a la propagación de enfermedades, según Finlay.


La microbióloga española Mireia Vallès, de la Universidad de Trento, en el norte de Italia
800 especies de bacterias
El nuevo trabajo apunta en esa misma dirección. Nuestros resultados refuerzan la hipótesis de que varias enfermedades y afecciones que actualmente se consideran no transmisibles deberían reevaluarse, afirman los autores en su estudio, publicado este miércoles en la revista Nature, vanguardia de la mejor ciencia mundial. Es la mayor investigación sobre la transmisión del microbioma humano llevada a cabo hasta la fecha.
Los firmantes se han fijado en más de 800 especies de bacterias, identificando las cepas ultraespecíficas de cada persona. Compartir un 8% es mucho, porque con quien no hemos estado en contacto tenemos cero, subraya Vallès, nacida hace 32 años en Vic (Barcelona). Su estudio confirma que el microbioma de la boca se transmite de manera diferente al de las profundidades del aparato digestivo. Por vía oral, el vehículo es la saliva, pero todavía no conocemos el mecanismo específico del intestinal. Podría ser por falta de higiene, por una transmisión fecal-oral que luego llega al intestino, pero no está claro, reconoce la microbióloga.

Un cultivo bacteriano.
En el macroestudio han participado investigadores de una decena de países, incluida la ingeniera agrónoma María Carmen Collado, del Instituto de Agroquímica y Tecnología de los Alimentos del CSIC, en Paterna (Valencia). Collado es especialista en la llamada transmisión vertical del microbioma, de madres a hijos. Ahora hemos visto que la transmisión horizontal, de persona a persona, es muy importante, mucho más de lo que inicialmente se había pensado, destaca.
El microbioma está en el punto de mira de la comunidad científica. Hace tres meses, un equipo de la Universidad de Yale (Estados Unidos) anunció que un microbio habitual en el intestino humano es sospechoso de desempeñar un importante papel en el desarrollo de cáncer colorrectal, el segundo tumor más letal en el mundo. Algunas cepas de esta bacteria, llamada Morganella morganii, producen unas moléculas tóxicas para el ADN humano que, inyectadas en ratones, provocan tumores. Otra bacteria frecuente en el estómago, la Helicobacter pylori, está asociada a un mayor riesgo de cáncer gástrico.
El equipo de Mireia Vallès ha detectado algunos microbios que se transmiten más que otros. Muchos ni siquiera tienen nombre todavía, pese a su aparente importancia, según explica la científica. Lo que nos sorprende en general es que hay algunas bacterias de las cuales sabemos muy poco, que nunca han sido cultivadas, y que están en la parte más alta del ranking [de microbios compartidos], advierte Vallès. Su grupo ha recurrido a la metagenómica, el análisis a gran escala de todo el material genético presente en las muestras de heces y saliva.
El microbiólogo Brett Finlay, pionero de la hipótesis, aplaude la nueva investigación, en la que no ha participado. Es un estudio fascinante, que se alimenta de lo que yo mismo planteé: que las enfermedades no transmisibles son potencialmente transmisibles a través del microbioma, opina este investigador de la Universidad de Columbia Británica, en Canadá. Estos resultados realmente refuerzan el concepto de que puedes adquirir microbios potencialmente malos [causantes de enfermedades] de otras personas de forma transmisible. Esto nos hace replantearnos las políticas contra las enfermedades no transmisibles, que actualmente representan la mayor parte de la morbilidad y la mortalidad en todo el mundo, argumenta Finlay. Elige bien a tus parejas, bromea.
El País de España
